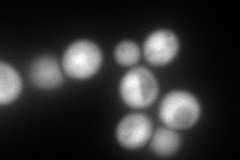
YGR135W
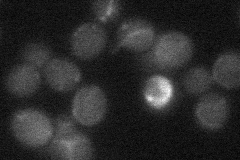
YGR135W
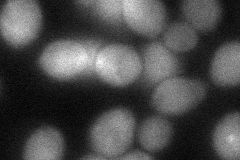
YGR135W
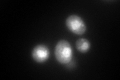
YGR135W
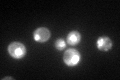
YGR135W

View description
Alpha 3 subunit of the 20S proteasome, the only nonessential 20S subunit; may be replaced by the alpha 4 subunit (Pre6p) under stress conditions to create a more active proteasomal isoform
Localization:
Intensity:
Fold change:
Significance:
-
C’ GFP library in SD

nucleus167.86 -
N' NOP1pr-GFP in SD

cytosol,nucleus173.652 -
N' TEF2pr-mCherry in SD
cytosol255.989 -
N' NATIVEpr-GFP in SD
below threshold17.726 -
N' TEF2pr-VC and Cyto-VN in SD
cytosol46.8232 -
C’ GFP library in SD+DTT
nucleus210.121.25No -
C’ GFP library in SD+H2O2

nucleus216.691.29No -
C’ GFP library in Starvation Media
nucleus172.131.02No -
C’ GFP library on the background of Pup2-DaMP

nucleus -
C’ GFP library on the background of CCT mutant

nucleus222.9041.32786No
